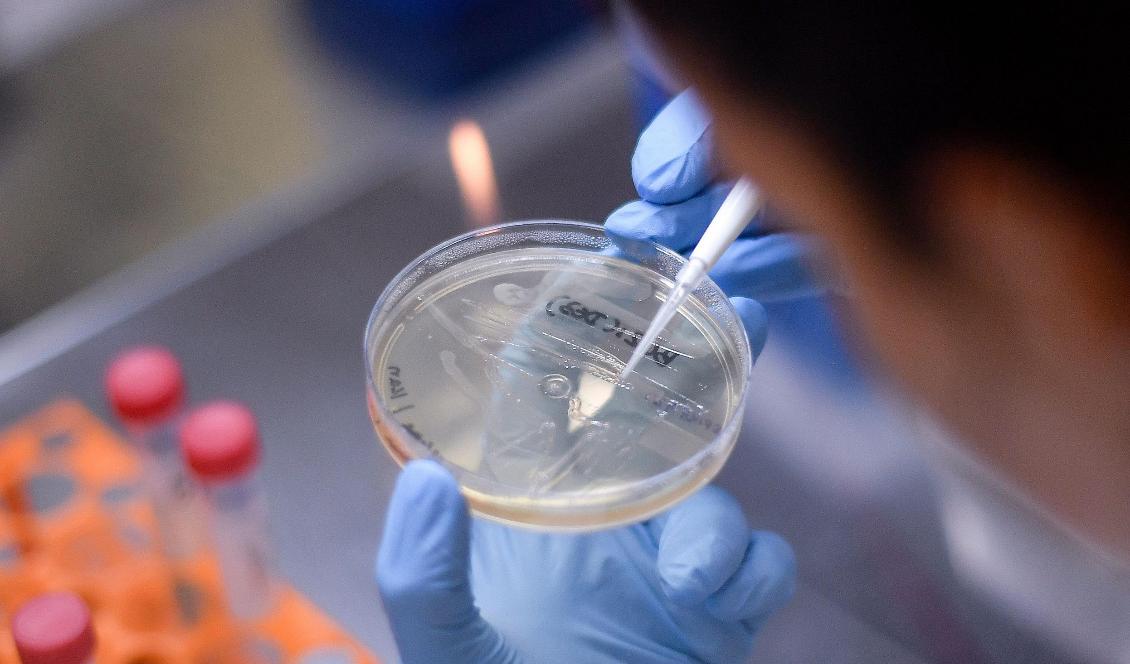
En kinesisk man har dömts till fängelse efter att ha stulit affärshemligheter för att sälja dem till Kina. Foto: Douglas Magno/AFP via Getty Images

Det hjälper inte att flytta till andra sidan jorden och byta medborgarskap; den som en gång i tiden har kunnat kallas kines betraktar Kinesiska kommunistpartiet som en av de sina och förväntar sig obrottslig lojalitet ifrån, oavsett vad personen själv tycker.
Kinas ledare Xi Jinping är tydlig med kursen. Det är dags för hans rike att inta en central roll på världsscenen och han använder bland annat ekonomin, militären, diplomatin och kulturen för att uppnå detta mål. Dessutom är exilkineser, genom en allians av allehanda aktörer styrda av den kommunistiska enhetsfronten, viktiga kuggar i detta enorma maskineri.
Det tidigare inåtvända Kina lägger numera stor vikt vid utrikesfrågor och en central del i detta är att engagera den stora kinesiska diasporan för att hjälpa kommunistpartiet uppnå sina internationella mål. Och regimen använder samma totalitära förhållningssätt utanför som innanför Kinas gränser. Detta gäller oavsett vilken nationalitet personerna har idag.
”Medlemmar av diasporan som motsätter sig regimen behandlas som kriminella och förrädare”, skriver Oscar Almén vid FOI (Totalförsvarets forskningsinstitut) i en rapport med titeln ”Kinas kommunistparti och diasporan: Pekings extraterritoriella styre”.
Eftersom Kina inte godkänner dubbla medborgarskap är en stor andel av utlandskineserna inte längre medborgare i Folkrepubliken. Men det spelar ingen roll för regimen.
”När Kinas ledare beskriver det kinesiska folket refererar de ... kontinuerligt till härkomst och blodslinje. Enligt denna uppfattning kan alla utländska medborgare med kinesisk härkomst inkluderas i den kinesiska nationen.” skriver Oscar Almén.
Och eftersom Kinas kommunistparti har smält samman begreppen nationen och partiet, så anses den som har kritiska synpunkter på regimen också vara negativ till landet.
Enligt kommunistpartiet är en person som en gång i tiden har varit kines alltid en kines. Det gäller även om det bara handlar om ett avlägset påbrå, flera generationer tillbaka. Det spelar ingen roll vad personerna själva anser, eller vad som står i deras pass. Det är den svenske medborgaren Gui Minhai exempel på.
Gui Minhai kidnappades av kinesiska säkerhetsagenter från sin semesterbostad i Thailand. Han drev bokförlag och bokhandel i Hongkong och arbetade med en bok om privata skandaler kring ledaren Xi Jinping. Kina har meddelat att Gui Minhai under tiden i fångenskap blivit kinesisk medborgare, men ingen har hört honom själv påstå att detta byte av medborgarskap verkligen har skett, eller att det har skett utan hot eller tvång.
Oscar Almén konstaterar: ”Kombinationen av etnisk nationalism och ett auktoritärt system är inte unikt för Kina, men Kinas globala inflytande, storleken på den kinesiska diasporan och den omfattande organisation som partistaten engagerar för att påverka kineser som bor utomlands gör att Kina sticker ut i jämförelse med andra auktoritära stater.”
Samtidigt som Kinas kommunistregim bestraffar och bortför utlandskineser som uppfattas som oppositionella, går lojala medlemmar av diasporan villigt regimens ärenden genom att exempelvis påverka politiken i landet de lever i till Kinas fördel.
Kinas intensifierade aktiviteter i andra länder, genom den osynliga Enhetsfronten, har orsakat flera konsekvenser på säkerhetsområdet, på både system- och individnivå. Det handlar bland annat om påverkan på andra länders inrikespolitik, säkerhetshot mot medborgare av kinesisk härkomst i andra länder, liksom mot utlänningar i Kina och inte minst ett underminerande av det internationella rättssystemet.
I rapporten listas sex säkerhetsrisker som Kinas utrikesaktiviteter kan innebära för andra länder.
1. Kinas kommunistparti kan direkt påverka andra länders politiker och beslutsfattare. När kommunistpartiets intressen står i konflikt med värdlandets nationella intressen kan beslutsfattare som påverkats av Kina underminera den nationella säkerheten. 2019 uppdagades att lokalpolitikern Lydia Lu som valts in i Nackas kommunfullmäktige och varit mycket engagerad i småföretagarfrågor haft kontakter med Enhetsfronten. Hon uteslöts ur KD men sitter kvar i fullmäktige som politisk vilde.
2. Stater kan inte garantera att medborgare av kinesiskt ursprung går säkra från sanktioner från Kinas kommunistparti. Sådana individer kan inte lita på att deras medborgarskap skyddar dem på samma sätt som det skyddar deras landsmän.
3. Medborgare av kinesisk härkomst kan falla offer för antikinesiska stämningar i samhället. Erfarenheter från Sydostasien har visat att detta kan leda till dödligt våld.
4. Enskilda medborgare kan bli negativt påverkade av den kinesiska partistaten när det uppstår försämrade bilaterala relationer. Ett exempel på det är den "kidnappningsdiplomati", där två kanadensiska män blivit fängslade i Kina, som Kina började med efter att Kanada grep det kinesiska telekombolaget Huaweis finanschef.
5. När Kina genomför utrikesaktiviteter i strid med den internationella rätten ifrågasätts dess respekt för nationalitetsprincipen. När etnicitet och arv är viktigare än den medborgerliga nationaliteten, hotar Kinas utrikesaktiviteter att underminera den internationella rätten.
6. Bortförande av brittiska medborgare från Hongkong och taiwaneser från länder i Afrika till Kina, visar att Peking saknar respekt för Hongkongs och Taiwans juridiska självständighet. Sådana aktiviteter bekräftar partiets strävan att utöka sin kontroll över dessa territorier.
Det finns flera organisationer som verkar på enhetsfrontens uppdrag i Sverige. En av dessa är China Council for the Promotion of Peaceful National Reunification (CCPPNR), som vill införliva Taiwan med Fastlandskina och är en officiell del av Departementet för enhetsfronten. År 2005 startades en svensk avdelning med syfte att samla den kinesiska diasporan kring kommunistpartiets målsättningar. Denna svenska gren av CCPPNR har flera gånger organiserat aktiviteter i Sverige för att stödja Kinas kommunistparti.
Visste du att vi även finns som papperstidning med veckoutgåva? Svenska Epoch Times – en traditionell nyhetstidning med klassisk, objektiv journalistik. Teckna din provprenumeration på papperstidningen idag – endast 99kr – klicka här för mer information.